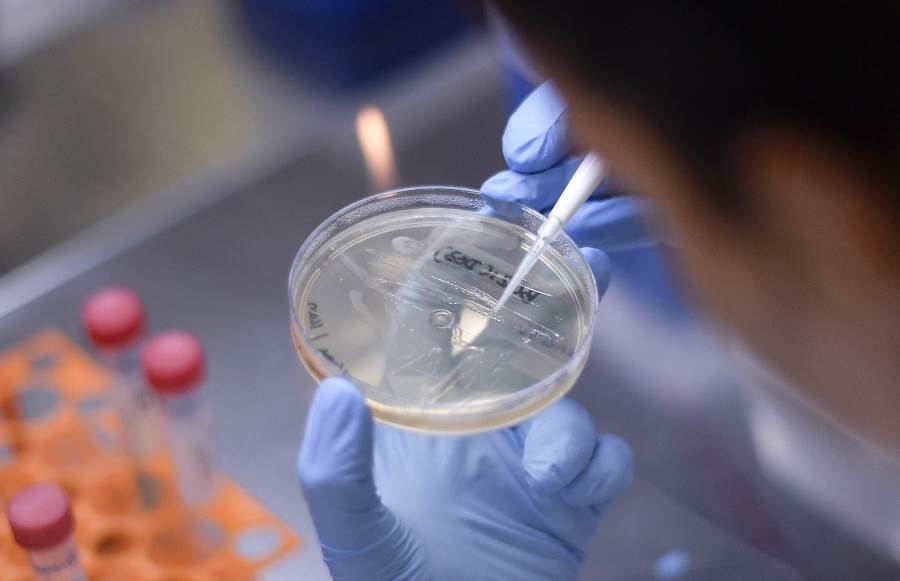
شركة ألمانية تطور لقاحا ضد كورونا بأقل من يورو .. إليكِ التفاصيل

خبر سار .. تسليم أول شحنات من لقاح شركة فايزر المضاد لكورونا فى 15 ديسمبر
ذكرت شبكة CNN الأمريكية أنه سيتم تسليم الشحنات الأولى من لقاح فيروس كورونا لشركة فايزر فى 15 ديسمبر، وفقًا لوثيقة عملية وارب سبيد وهي مبادرة الحكومة الأمريكية لتطوير لقاحات فيروس كورونا، والوثيقة التى قدمت إلى المحافظين قبل مكالمة مع نائب الرئيس الأمريكي، قدرت أيضًا أن الشحنة الأولى من لقاح مودرنا سيتم تسليمها في 22 ديسمبر.
تتوقف تواريخ التوزيع هذه على قرار تتخذه إدارة الغذاء والدواء الأمريكية للسماح باستخدام كل لقاح في حالات الطوارئ، وقد قدمت شركة Pfizer طلبًا إلى FDA في 20 نوفمبر، وقدمت شركة Moderna طلبًا في 30 نوفمبر.
وستجتمع اللجنة الاستشارية للقاحات والمنتجات البيولوجية ذات الصلة التابعة لإدارة الغذاء والدواء، وهى لجنة من الخبراء المستقلين، فى 10 ديسمبر لمراجعة بيانات شركة فايزر وتقديم توصية إلى إدارة الغذاء والدواء بشأن السماح باللقاح.
حددت الوثيقة نافذة مدتها أربعة أيام بين 11 ديسمبر و 14 ديسمبر للمراجعة من قبل إدارة الغذاء والدواء واللجنة الاستشارية لممارسات التحصين التابعة لمركز السيطرة على الأمراض والوقاية منها، والتى تقدم توصيات حول من يجب أن يتلقى اللقاح أولاً.
وفي 15 ديسمبر، سيتم تسليم الجرعات الأولى من لقاح فيروس كورونا من شركة فايزر، وفقًا للخطوط العريضة للوثيقة.
بعد ذلك من المقرر أن تنظر إدارة الغذاء والدواء في لقاح مودرنا في 17 ديسمبر بعد فترة مراجعة مدتها أربعة أيام من 18 ديسمبر إلى 21 ديسمبر، وذكرت الوثيقة أن أول شحنات لقاح موديرنا من المتوقع أن يتم تسليمها في 22 ديسمبر.
تضمنت الوثيقة توقعات لتصنيع اللقاح، حيث سيتم إنتاج 22.5 مليون جرعة من لقاح فايزر، و18 مليون جرعة من لقاح مودرنا في ديسمبر.
وتم تضمين قائمة "المهام الأساسية" للمحافظين لإكمالها بحلول 4 ديسمبر، بما في ذلك الطلب المسبق للقاحات Pfizer، وتسجيل مقدمي الخدمات في برنامج لقاح كورونا واستكمال الخطط الصغيرة للتوزيع والإدارة.